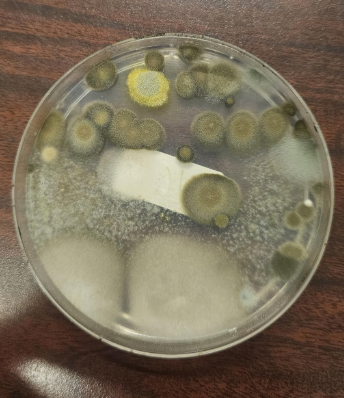

User28823
do not go gentle into that good night
- Joined
- Aug 7, 2022
- Posts
- 33,964
- Reputation
- 61,067

fuck... i just moved here, and im gonna have to get a new house now
@asdvek @Tyler1 @shieldzz
Follow along with the video below to see how to install our site as a web app on your home screen.

Note: this_feature_currently_requires_accessing_site_using_safari
mold test kit, its full of moldthis doesn't even make sense
holy fucking retarded advice.Mold is primal. It detoxes you from heavy metals. Eating that could possibly make your eye color lighter and you could detox from heavy metals.
@thereallegend @IAMNOTANINCEL
Mold is primal. It detoxes you from heavy metals. Eating that could possibly make your eye color lighter and you could detox from heavy metals.
@thereallegend @IAMNOTANINCEL

If the mold is growing on something man made then the mold is toxicMold is primal. It detoxes you from heavy metals. Eating that could possibly make your eye color lighter and you could detox from heavy metals.
@thereallegend @IAMNOTANINCEL
the keyboard ur typing on is man madeIf the mold is growing on something man made then the mold is toxic
Yes, moldy berries are good for detox thoIf the mold is growing on something man made then the mold is toxic
Dude you just unlocked a new fear for me I never tested my old ass apartment for moldView attachment 4179129
fuck... i just moved here, and im gonna have to get a new house now
@asdvek @Tyler1 @shieldzz
Talk to @romanstock. He really knows how to get rid of mould. He inspired me to be a human being.View attachment 4179129
fuck... i just moved here, and im gonna have to get a new house now
@asdvek @Tyler1 @shieldzz
@romanstock GTFIH !!!!!Talk to @romanstock. He really knows how to get rid of mould. He inspired me to be a human being.
Clean the air unitsView attachment 4179129
fuck... i just moved here, and im gonna have to get a new house now
@asdvek @Tyler1 @shieldzz
Yes I've done them. Rasperberries and blackerries... Just let the sit bro... eventually the mold growsYes, moldy berries are good for detox tho
Have you tried them
And what berries are ideal & how to make them moldy
I'm wearing silver lined clothing and blue light blocking glasses to protect myself from the negative side effects of technologythe keyboard ur typing on is man made
the cpu operating your device is manmade
the internet is man made
brutal....
How was the detox? Did you vomit/diarrhea etcYes I've done them. Rasperberries and blackerries... Just let the sit bro... eventually the mold grows
I've vomited before form megadosing "organic" blackberriesHow was the detox? Did you vomit/diarrhea etc
Were they sprayed
man made clothing and glasses with microplasticsI'm wearing silver lined clothing and blue light blocking glasses to protect myself from the negative side effects of technology
@romanstock GTFIH !!!!!
my showerDo you know where it's coming from? Check the walls near any water fixture for 'bubbling'. Check under the sink, often the area between the metal sink and the wooden bench isn't sealed and there's mould under there.
my shower
Legit. Eating moldy berries is very well reported to cure autismMold is primal. It detoxes you from heavy metals. Eating that could possibly make your eye color lighter and you could detox from heavy metals.
@thereallegend @IAMNOTANINCEL
oh yeah? show me ur raw moldy berries rnLegit. Eating moldy berries is very well reported to cure autism
However if it grows on toxic shit like painted walls don't consume it but if it grows on raw natural food or something like wood no problem
Its like grassfed cow vs soy fed cow
I don't have any rn but i can take some off the tree tomorrow and report back in like 2 weeksoh yeah? show me ur raw moldy berries rn
yeah that would be some real good stuff. i wanna see u take those raw moldy balls in ur mouthI don't have any rn but i can take some off the tree tomorrow and report back in like 2 weeks